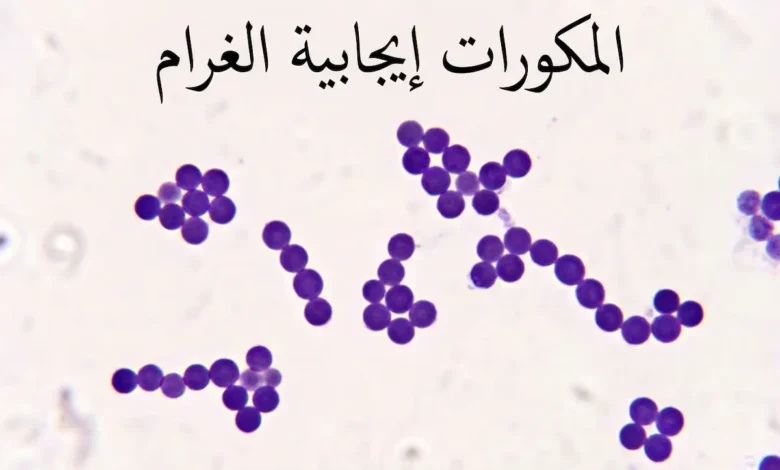
صورة مجهرية واقعية لمكورات إيجابية الغرام بنفسجية اللون مرتّبة في عناقيد وسلاسل بعد صبغة جرام
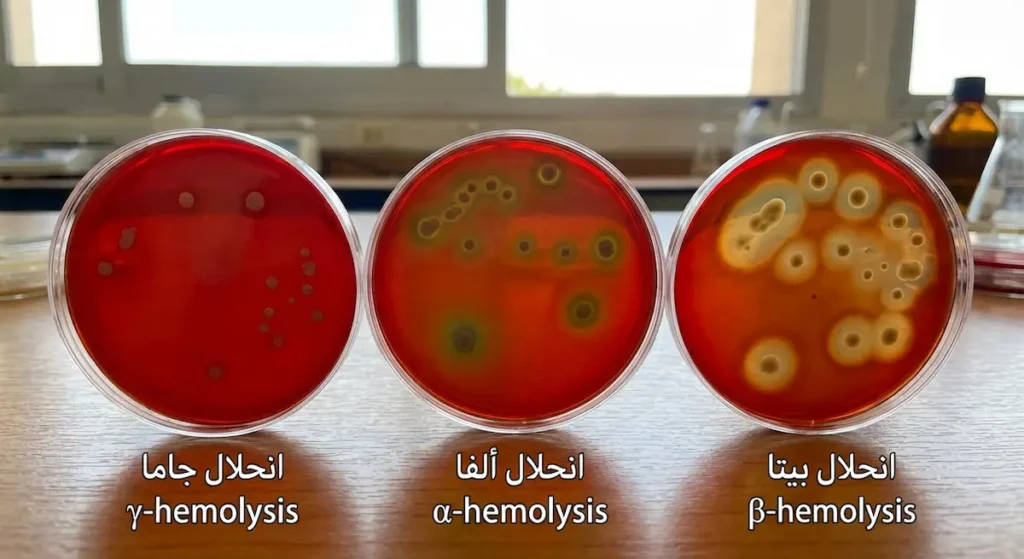
ثلاثة أطباق آجار دم تُظهر أنماط انحلال الدم الثلاثة: بيتا (تحلّل كامل)، ألفا (تحلّل جزئي بلون أخضر)، وجاما (لا انحلال)

المكورات إيجابية الغرام: لماذا تُهيمن على عالم العدوى البكتيرية؟
ما الذي يجعل هذه البكتيريا الأخطر في المستشفيات والمجتمع؟
المكورات إيجابية الغرام هي بكتيريا كروية الشكل تحتفظ بصبغة البنفسج البلوري عند إجراء صبغة جرام، بسبب سماكة طبقة الببتيدوجليكان في جدارها الخلوي. تشمل أجناساً ذات أهمية طبية قصوى كالمكورات العنقودية (Staphylococcus) والمكورات العقدية (Streptococcus) والمكورات المعوية (Enterococcus)، وتسبّب طيفاً واسعاً من العدوى يمتد من الالتهابات الجلدية البسيطة إلى تسمم الدم المميت.
هل سبق أن سمعت طبيبك يقول “العدوى ناتجة عن بكتيريا موجبة الجرام” فشعرت بأنك أمام لغة مشفّرة لا علاقة لك بها؟ أنت لست وحدك. كثير من طلاب الطب أنفسهم يجدون صعوبة في ترتيب هذا العالم المعقد داخل رؤوسهم خلال سنوات الدراسة الأولى. لقد كتبتُ هذا المقال تحديداً ليكون المرجع الذي تمنيت لو وجدته حين كنت أدرس علم الأحياء الدقيقة (Microbiology) لأول مرة. ستجد هنا كل ما تحتاجه لفهم المكورات إيجابية الغرام من الصفر: بنيتها، تصنيفها، أمراضها، تشخيصها، ومقاومتها للمضادات الحيوية — بلا تعقيد مُفرط ولا تبسيط مُخلّ.
📌 خلاصة المقال في دقيقة واحدة
🔬 حقائق علمية جوهرية
- المكورات إيجابية الغرام تحتفظ باللون البنفسجي بسبب سماكة طبقة الببتيدوجليكان التي تُشكّل ~90% من جدارها الخلوي.
- تنقسم إلى عنقوديات (إيجابية الكتالاز) وعقديات ومعويات (سلبية الكتالاز) — وهذا الاختبار الوحيد يفتح باب التشخيص بالكامل.
- المكورات العنقودية الذهبية (S. aureus) هي الأخطر، وتملك ترسانة سموم تشمل: كواجولاز، بروتين A، وذيفانات معوية مقاومة للحرارة.
🚨 تحذيرات حرجة
- MRSA تقاوم جميع مضادات البيتا لاكتام — ومعدلاتها في دول الخليج تتراوح بين 12–40% في وحدات العناية المركزة.
- العقدية المقيّحة تقتل أكثر من 500,000 شخص سنوياً عالمياً بسبب مضاعفات الحمى الروماتيزمية.
- المكورات المعوية المقاومة للفانكومايسين (VRE) قادرة على نقل جينات المقاومة أفقياً لبكتيريا أخرى.
✅ خطوات عملية فورية
- في المختبر: ابدأ دائماً بصبغة جرام → كتالاز → كواجولاز. هذه السلسلة تكفي لتشخيص ~70% من الحالات مبدئياً.
- في المستشفى: طالِب بنظافة اليدين قبل أي تماس طبي — الالتزام لا يتجاوز 40–60% بدون رقابة.
- للحوامل: فحص مسحة GBS بين الأسبوعين 35 و37 إجراء وقائي منقذ لحياة المواليد.
لماذا تُسمّى “إيجابية الغرام” وما سرّ اللون البنفسجي؟

تخيّل أنك فنّي مختبر في مستشفى سعودي، ووصلتك عيّنة دم من مريض يعاني حمّى شديدة. أول خطوة ستقوم بها هي تحضير شريحة مجهرية وإجراء صبغة جرام (Gram Stain). تضع البنفسج البلوري (Crystal Violet)، ثم اليود (Iodine)، ثم تغسل بالكحول، وأخيراً تضيف الصبغة المقابلة السافرانين (Safranin). لو ظهرت البكتيريا بلون بنفسجي غامق تحت المجهر — فأنت أمام بكتيريا إيجابية الجرام. لكن لماذا تحتفظ بهذا اللون بينما تفقده البكتيريا سلبية الغرام؟
السرّ يكمن في جدار الخلية البكتيرية. المكورات إيجابية الغرام تمتلك طبقة سميكة جداً من الببتيدوجليكان (Peptidoglycan) يتراوح سمكها بين 20 و80 نانومتراً، مقارنةً بطبقة رقيقة لا تتجاوز 5-10 نانومترات في البكتيريا سلبية الغرام. هذه الطبقة السميكة تعمل كإسفنجة تمتصّ معقّد البنفسج البلوري واليود وتحبسه بإحكام. وحين يأتي دور الكحول — الذي يُفترض أن يُزيل الصبغة — فإنه يُسبّب جفاف طبقة الببتيدوجليكان وانقباضها، مما يُغلق المسامات ويمنع خروج الصبغة.
🔬 معلومة مخبرية
طبقة الببتيدوجليكان في المكورات إيجابية الغرام تُشكّل نحو 90% من وزن الجدار الخلوي الجاف، بينما لا تتجاوز 10% في البكتيريا سلبية الغرام. هذا الفرق الهائل هو ما يجعل صبغة جرام — التي ابتكرها الطبيب الدنماركي هانس كريستيان غرام عام 1884 — أداةً تشخيصية فعّالة حتى اليوم بعد أكثر من 140 عاماً.
📌 اقرأ أيضاً: البكتيريا في جسمك أكثر من خلاياك! كيف تعيش معك دون أن تدري؟
| الخاصية | إيجابية الغرام | سلبية الغرام |
|---|---|---|
| سمك طبقة الببتيدوجليكان | 20–80 nm (سميكة) | 5–10 nm (رقيقة) |
| نسبة الببتيدوجليكان من الجدار | ~90% | ~10% |
| أحماض التيكويك (Teichoic Acids) | موجودة | غائبة |
| الغشاء الخارجي (Outer Membrane) | غائب | موجود |
| عديد السكاريد الشحمي (LPS/Endotoxin) | غائب | موجود |
| الفراغ المحيط بالبلازما (Periplasmic Space) | ضيق أو غائب | واسع وواضح |
| اللون بعد صبغة جرام | بنفسجي (Crystal Violet) | أحمر/وردي (Safranin) |
| المصدر: National Center for Biotechnology Information (NCBI) – Medical Microbiology, 4th edition | ||
ما دور أحماض التيكويك في بنية هذه البكتيريا ومناعتها؟

لا يقتصر جدار الخلية البكتيرية في المكورات إيجابية الغرام على الببتيدوجليكان وحده. هناك مكوّن آخر بالغ الأهمية يُسمّى أحماض التيكويك (Teichoic Acids)، وهي بوليمرات من الجليسرول أو الريبيتول مرتبطة بمجموعات فوسفات. تنقسم إلى نوعين رئيسين: أحماض تيكويك جدارية (Wall Teichoic Acids) مرتبطة مباشرة بالببتيدوجليكان، وأحماض ليبوتيكويك (Lipoteichoic Acids) مثبّتة في غشاء البلازما وتمتد عبر طبقة الببتيدوجليكان نحو السطح.
فما وظيفة هذه الأحماض؟ إنها تُؤدي أدواراً متعددة في آنٍ واحد. فهي تُعطي سطح الخلية شحنة سالبة تُنظّم مرور الأيونات عبر الجدار، وتُساهم في الالتصاق بالأسطح والأنسجة البشرية. كما أنها تعمل كمستضدات (Antigens) يتعرّف عليها جهاز المناعة البشري، مما يجعلها عاملاً محورياً في إثارة الاستجابة الالتهابية. وقد أثبتت دراسة منشورة في مجلة Annual Review of Microbiology عام 2020 أن أحماض التيكويك تلعب دوراً محورياً في مقاومة بعض المكورات العنقودية للمضادات الحيوية من عائلة البيتا لاكتام، من خلال تنظيم نشاط إنزيمات بناء الجدار الخلوي (Brown, S., Santa Maria, J. P., & Walker, S., 2013; مراجعة محدّثة 2020).
كيف تُصنَّف المكورات إيجابية الغرام علمياً؟

التصنيف العلمي (Taxonomy) لهذه المجموعة البكتيرية يبدأ باختبار بسيط لكنه جوهري: اختبار الكتالاز (Catalase Test). هذا الاختبار يكشف عن وجود إنزيم الكتالاز الذي يُحلّل بيروكسيد الهيدروجين (H₂O₂) إلى ماء وأكسجين. ضع قطرة من بيروكسيد الهيدروجين على مستعمرة بكتيرية؛ إن ظهرت فقاعات فوراً فالنتيجة إيجابية، وإن لم تظهر فالنتيجة سلبية.
هذا الاختبار الوحيد يقسم عالم المكورات إيجابية الغرام إلى فرعين كبيرين: المكورات العنقودية (Staphylococci) إيجابية الكتالاز من جهة، والمكورات العقدية (Streptococci) والمكورات المعوية (Enterococci) سلبية الكتالاز من جهة أخرى. فهم هذا التقسيم الثنائي هو المفتاح الذهبي الذي يفتح لك باب التشخيص المخبري بأكمله.
المكورات العنقودية (Staphylococci): عناقيد العنب تحت المجهر

حين تنظر إلى المكورات العنقودية تحت المجهر بعد صبغة جرام، ستلاحظ شكلاً مميزاً يُشبه عناقيد العنب — ومن هنا جاءت التسمية اليونانية “Staphyle” التي تعني عنقود العنب. هذا الترتيب العنقودي ينتج عن انقسام الخلية في مستويات متعددة عشوائية.
أهم الأنواع في هذه العائلة نوعان. الأول هو المكورات العنقودية الذهبية (Staphylococcus aureus)، وسُمّيت “ذهبية” لأن مستعمراتها تظهر بلون أصفر ذهبي على أطباق الزراعة. هذا النوع هو الأكثر شراسةً وخطورة، ويمتلك ترسانة من عوامل الضراوة (Virulence Factors) لا تُضاهيها بكتيريا أخرى تقريباً.
النوع الثاني هو المكورات العنقودية الجلدية (Staphylococcus epidermidis)، وهي في الأصل جزء من الفلورا الطبيعية للجلد البشري. لكنها تتحوّل إلى ممرض انتهازي (Opportunistic Pathogen) خطير حين تجد طريقها إلى مجرى الدم عبر القسطرة الوريدية أو المفاصل الصناعية.
💡 حقيقة سريعة
الفرق بين المكورات العنقودية والمكورات العقدية تحت المجهر واضح للعين المدرّبة: العنقوديات تتجمّع كعناقيد عنب، بينما العقديات تصطفّ كحبّات مسبحة في سلاسل. هذا الفرق البصري البسيط هو أول خطوة في التشخيص المخبري التفريقي بينهما.
المصدر: American Society for Microbiology (ASM) – Manual of Clinical Microbiology
📌 اقرأ أيضاً: عدد الكائنات المجهرية في جسم الإنسان: اكتشافات مذهلة
المكورات العقدية (Streptococci): سلاسل قاتلة
على النقيض من ذلك، تنقسم المكورات العقدية في مستوى واحد فقط، مما يُنتج ترتيباً يُشبه السلاسل أو المسابح تحت المجهر. ومن هنا جاء الاسم اليوناني “Streptos” بمعنى سلسلة ملتوية. لكن تصنيف المكورات العقدية أعقد بكثير من مجرد النظر تحت المجهر؛ إذ يعتمد على نظامين رئيسين.
النظام الأول هو تصنيف لانسفيلد (Lancefield Grouping) الذي ابتكرته عالمة الأحياء الدقيقة ريبيكا لانسفيلد في ثلاثينيات القرن العشرين. يعتمد هذا التصنيف على نوع الكربوهيدرات الموجود في جدار الخلية (المستضد C)، ويُقسّم العقديات إلى مجموعات تُرمز بأحرف لاتينية من A إلى U. أشهرها المجموعة A (العقدية المقيّحة S. pyogenes) والمجموعة B (العقدية القاطعة للدر S. agalactiae).
النظام الثاني يعتمد على نمط انحلال الدم (Hemolysis) عند زراعة البكتيريا على آجار الدم (Blood Agar):
- انحلال بيتا (β-hemolysis): تحلّل كامل لكريات الدم الحمراء حول المستعمرة، ويظهر كمنطقة شفافة صافية. وهذا هو النمط الأخطر سريرياً.
- انحلال ألفا (α-hemolysis): تحلّل جزئي يُنتج لوناً أخضر حول المستعمرة بسبب تحويل الهيموجلوبين إلى ميتهيموجلوبين.
- انحلال جاما (γ-hemolysis): لا انحلال على الإطلاق. وتُسمّى أحياناً “غير حالّة للدم” (Non-hemolytic).
| المعيار | المكورات العنقودية (Staphylococci) | المكورات العقدية (Streptococci) | المكورات المعوية (Enterococci) |
|---|---|---|---|
| اختبار الكتالاز | إيجابي (+) | سلبي (−) | سلبي (−) |
| الشكل المجهري | عناقيد (Clusters) | سلاسل (Chains) | سلاسل قصيرة أو أزواج |
| تحمل ملح NaCl بتركيز 6.5% | نعم | لا | نعم |
| النمو في الصفراء (Bile Esculin) | سلبي عادة | سلبي عادة | إيجابي (+) |
| أشهر الأنواع المُمرضة | S. aureus, S. epidermidis | S. pyogenes, S. pneumoniae | E. faecalis, E. faecium |
| المصدر: American Society for Microbiology (ASM) – Manual of Clinical Microbiology | |||
ما الذي يجعل المكورات العنقودية الذهبية “الملك المتوّج” بين الممرضات؟

لا أبالغ حين أصف المكورات العنقودية الذهبية (Staphylococcus aureus) بأنها أخطر بكتيريا كروية يواجهها الأطباء يومياً. هذه البكتيريا تمتلك ترسانة من عوامل الضراوة تجعلها قادرة على إحداث طيف واسع من الأمراض يبدأ من دمّل صغير على الجلد وينتهي بالتهاب شغاف القلب (Endocarditis) وتسمم الدم (Septicemia).
فما الأسلحة التي تمتلكها هذه البكتيريا؟ أوّلها إنزيم الكواجولاز (Coagulase)، وهو الإنزيم الذي يُميّزها عن جميع العنقوديات الأخرى. يعمل هذا الإنزيم على تحويل الفيبرينوجين إلى فيبرين، مما يُشكّل درعاً من الجلطات الدقيقة حول البكتيريا يحميها من خلايا المناعة البيضاء. ثانيها البروتين A (Protein A) الموجود على سطح الخلية، والذي يرتبط بالجزء Fc من الأجسام المضادة IgG بشكل معكوس — أي أنه يُمسك بالأجسام المضادة من “ذيلها” بدلاً من “رأسها”، فيُبطل قدرتها على تنشيط البلعمة (Opsonization).
بالإضافة إلى ذلك، تُنتج المكورات العنقودية الذهبية مجموعة من السموم المتخصصة. منها السموم المعوية (Enterotoxins) التي تُسبّب تسمماً غذائياً يظهر خلال 1-6 ساعات من تناول الطعام الملوّث — وهذه السموم مقاومة للحرارة، أي أن طبخ الطعام لا يُبطلها. ومنها سمّ التقشّر (Exfoliatin) الذي يُسبّب متلازمة الجلد المسلوخ (Scalded Skin Syndrome) عند الرضّع. ومنها أيضاً ذيفان متلازمة الصدمة السمّية (TSST-1) الذي يعمل كمستضد فائق (Superantigen) يُنشّط نسبة هائلة من الخلايا التائية دفعة واحدة، مما يُسبّب عاصفة سيتوكينية قد تكون قاتلة.
🏥 واقع سعودي
في المملكة العربية السعودية، أظهرت بيانات برنامج مكافحة العدوى في عدة مستشفيات كبرى أن المكورات العنقودية الذهبية المقاومة للميثيسيلين (MRSA) تُشكّل تحدياً متصاعداً، خاصة في وحدات العناية المركزة. وقد أكّد تقرير صادر عن وزارة الصحة السعودية عام 2023 على أهمية تطبيق بروتوكولات نظافة اليدين وعزل المرضى المصابين كخط دفاع أول.
📌 اقرأ أيضاً: علم الأمراض (Pathology): دراسة الأمراض وتأثيرها على الجسم
ماذا عن العنقوديات سلبية الكواجولاز؟

العنقوديات سلبية الكواجولاز (Coagulase-Negative Staphylococci – CoNS) كانت تُعَدُّ تاريخياً بكتيريا غير ممرضة أو “ملوّثات” عند ظهورها في زراعة الدم. لكن هذا التصوّر تغيّر جذرياً مع تقدّم الطب الحديث وازدياد استخدام الأجهزة الطبية المزروعة (Implanted Medical Devices).
فالمكورات العنقودية الجلدية (S. epidermidis) على سبيل المثال، تتميّز بقدرة فائقة على تكوين الأغشية الحيوية (Biofilms) على أسطح القسطرة الوريدية المركزية، والصمامات القلبية الصناعية، والمفاصل الصناعية. هذه الأغشية الحيوية تُشكّل حصناً بيولوجياً يحمي البكتيريا من المضادات الحيوية وخلايا المناعة معاً، مما يجعل علاج هذه العدوى صعباً للغاية ويستلزم في كثير من الأحيان إزالة الجهاز الطبي جراحياً.
ما الأمراض التي تُسببها المكورات العقدية وكيف تختلف أنواعها؟
المجموعة A: العقدية المقيّحة (Streptococcus pyogenes) — القاتلة الصامتة

المكورات العقدية من المجموعة A — واسمها العلمي العقدية المقيّحة (Streptococcus pyogenes) — هي المسؤولة عن التهاب البلعوم العقدي (Strep Throat) الذي يُصيب ملايين الأطفال سنوياً حول العالم. قد يبدو التهاب الحلق أمراً عادياً، لكن خطورة هذه البكتيريا لا تكمن في العدوى الأولية بقدر ما تكمن في مضاعفاتها المناعية اللاحقة.
إن لم يُعالَج التهاب البلعوم العقدي بالمضاد الحيوي المناسب (عادةً البنسلين أو الأموكسيسيلين)، فقد يُؤدي إلى الحمى الروماتيزمية (Rheumatic Fever) التي تُهاجم فيها الأجسام المضادة أنسجة القلب بالخطأ — فيما يُعرف بالتفاعل المتصالب (Molecular Mimicry) — مما يُسبّب تلفاً دائماً في صمامات القلب. كما قد يُسبّب التهاب كبيبات الكلى التالي للعقديات (Post-streptococcal Glomerulonephritis).
لكن الوجه الأكثر رعباً لهذه البكتيريا هو التهاب اللفافة الناخر (Necrotizing Fasciitis)، المعروف إعلامياً بـ”البكتيريا آكلة اللحم”. في هذه الحالة، تغزو البكتيريا الأنسجة الرخوة العميقة وتُدمّرها بسرعة مذهلة قد تصل إلى 2-3 سنتيمترات في الساعة، وتحمل نسبة وفيات تتراوح بين 20% و40% حتى مع العلاج المكثف.
وقد أثبتت دراسة منشورة في مجلة The Lancet Infectious Diseases عام 2019 أن معدلات الإصابة بعدوى العقدية المقيّحة الغازية (Invasive GAS) آخذة في الارتفاع عالمياً، مع ظهور سلالات أكثر شراسة تحمل جينات سموم جديدة (Lynskey, S. J., et al., 2019).
⚡ صدمة رقمية
وفقاً لمنظمة الصحة العالمية (WHO)، تُسبّب العقدية المقيّحة وحدها أكثر من 500,000 حالة وفاة سنوياً حول العالم، معظمها في الدول النامية بسبب الحمى الروماتيزمية وأمراض القلب الروماتيزمية. هذا الرقم يجعلها من أكثر مسبّبات الوفاة البكتيرية المُهمَلة عالمياً.
المصدر: World Health Organization (WHO) – Rheumatic Heart Disease Fact Sheet
📌 اقرأ أيضاً: أمراض القلب: ما الذي يجب أن تعرفه لحماية قلبك؟
المجموعة B: العقدية القاطعة للدر (Streptococcus agalactiae) — عدوّ المواليد

المكورات العقدية من المجموعة B (Group B Strep – GBS) تُستوطن المهبل والجهاز الهضمي لدى نحو 20-30% من النساء البالغات دون أن تُسبّب لهن أي أعراض. لكنها تتحوّل إلى خطر داهم أثناء الولادة؛ إذ يمكن أن تنتقل إلى المولود أثناء مروره عبر قناة الولادة.
عند حديثي الولادة، تُسبّب GBS شكلين من العدوى. الشكل المبكر يظهر خلال الأسبوع الأول ويتجلّى بتسمم الدم (Sepsis) والتهاب الرئة (Pneumonia). والشكل المتأخر يظهر بعد الأسبوع الأول حتى عمر ثلاثة أشهر، ويتجلّى غالباً بالتهاب السحايا (Meningitis) الذي قد يُخلّف إعاقات عصبية دائمة.
من هنا تأتي أهمية فحص مسحة المهبل والمستقيم للحوامل بين الأسبوعين 35 و37 من الحمل، وإعطاء المضاد الحيوي الوريدي (عادةً البنسلين) أثناء المخاض للأمهات الحاملات للبكتيريا. هذا البروتوكول الوقائي — المُطبّق في المملكة العربية السعودية ومعظم الدول المتقدمة — أدّى إلى انخفاض كبير في معدلات العدوى المبكرة عند حديثي الولادة.
📌 اقرأ أيضاً: طب الأطفال (Pediatrics): التخصص، الأمراض، والرعاية
العقدية الرئوية (Streptococcus pneumoniae): عدوّ الرئة والأذن الأول

العقدية الرئوية — المعروفة أيضاً بالمكورة الرئوية (Pneumococcus) — هي السبب الأول للالتهاب الرئوي المكتسب من المجتمع (Community-Acquired Pneumonia) عند البالغين، والسبب الأول لالتهاب الأذن الوسطى (Otitis Media) عند الأطفال.
تتميّز هذه البكتيريا بمحفظة عديدة السكاريد (Polysaccharide Capsule) سميكة تُشكّل عامل الضراوة الأهم لديها، لأنها تمنع البلعمة (Phagocytosis) بفاعلية عالية. لقد حُدّد أكثر من 100 نمط مصلي (Serotype) مختلف بناءً على تركيب هذه المحفظة، وهذا ما يجعل تطوير لقاح شامل أمراً معقداً.
لكن النجاح الطبي في هذا الملف ملحوظ. فلقاح المكورات الرئوية المقترن (PCV13) الذي يُعطى ضمن جدول التطعيمات الروتينية في السعودية أسهم في خفض معدلات التهاب السحايا والالتهاب الرئوي عند الأطفال دون سنّ الخامسة. بالمقابل، يُنصح كبار السن وأصحاب الأمراض المزمنة بأخذ لقاح PPSV23 الذي يُغطّي أنماطاً مصلية أوسع.
🔎 الجدير بالذكر
العقدية الرئوية تُعَدُّ سلبية الكتالاز كبقية العقديات — لكنها تختلف عنها بحساسيتها لمادة الأوبتوشين (Optochin) وبظاهرة الذوبان في الصفراء (Bile Solubility). هاتان الخاصيتان هما مفتاح التمييز بينها وبين العقديات الأخرى ألفا-الحالّة للدم في المختبر.
المكورات المعوية (Enterococcus): من ساكن هادئ إلى عدوّ مقاوم

المكورات المعوية كانت تُصنَّف تاريخياً ضمن المكورات العقدية من المجموعة D، لكنها نُقلت لاحقاً إلى جنس مستقل (Enterococcus) بناءً على اختلافات جينية وبيوكيميائية جوهرية. أشهر نوعين هما المكورة المعوية البرازية (E. faecalis) والمكورة المعوية الطيرية (E. faecium).
هذه البكتيريا تعيش طبيعياً في الأمعاء البشرية دون أن تُسبّب أي ضرر. لكنها تتحوّل إلى ممرض خطير في المستشفيات، خاصة لدى المرضى ذوي المناعة الضعيفة، وتُسبّب عدوى المسالك البولية (UTI)، والتهاب الشغاف (Endocarditis)، وعدوى الجروح الجراحية. ما يجعلها مرعبة حقاً هو مقاومتها الطبيعية والمكتسبة لعدد كبير من المضادات الحيوية، بما فيها الأمينوجليكوزيدات والسيفالوسبورينات.
| النوع | مجموعة لانسفيلد | نمط انحلال الدم | أبرز الأمراض | الفئة الأكثر عرضة |
|---|---|---|---|---|
| S. pyogenes | المجموعة A | بيتا (β) | التهاب البلعوم، الحمى القرمزية، التهاب اللفافة الناخر، الحمى الروماتيزمية | الأطفال والبالغون |
| S. agalactiae | المجموعة B | بيتا (β) | تسمم الدم عند حديثي الولادة، التهاب السحايا | حديثو الولادة والحوامل |
| S. pneumoniae | لا تصنف ضمن لانسفيلد | ألفا (α) | الالتهاب الرئوي، التهاب الأذن الوسطى، التهاب السحايا | الأطفال وكبار السن |
| E. faecalis / E. faecium | المجموعة D (سابقاً) | جاما (γ) غالباً | عدوى المسالك البولية، التهاب الشغاف، عدوى الجروح | المرضى المنومون في المستشفيات |
| المصدر: Centers for Disease Control and Prevention (CDC) – Group A Streptococcal Disease | ||||
كيف يتمّ التشخيص المخبري للمكورات إيجابية الغرام؟

هذا القسم هو ما أعتبره “الخوارزمية الذهبية” التي يجب أن يحفظها كل طالب طب وفنّي مختبر عن ظهر قلب. التشخيص يتبع خطوات منهجية تبدأ من العام وتتدرّج نحو الخاص.
الخطوة الأولى هي صبغة جرام والفحص المجهري. هل البكتيريا مكوّرات إيجابية الغرام؟ إن كانت كذلك، انتقل إلى الخطوة التالية.
الخطوة الثانية هي الزراعة البكتيرية. تُزرع العيّنة على آجار الدم (Blood Agar) لملاحظة نمط انحلال الدم. كما يُمكن استخدام آجار المانيتول المالح (Mannitol Salt Agar – MSA) وهو وسط انتقائي للمكورات العنقودية بسبب تركيز الملح العالي (7.5% NaCl) الذي يمنع نمو معظم البكتيريا الأخرى.
الخطوة الثالثة هي الاختبارات البيوكيميائية التفريقية، وهنا يأتي ما يُسمّيه الأساتذة “شجرة القرار التشخيصية”:
- اختبار الكتالاز: إيجابي = عنقوديات. سلبي = عقديات أو معويات.
- اختبار الكواجولاز (للعنقوديات): إيجابي = S. aureus. سلبي = CoNS.
- حساسية نوفوبيوسين (Novobiocin) (للعنقوديات سلبية الكواجولاز): حساسة = S. epidermidis. مقاومة = S. saprophyticus.
- حساسية الباسيتراسين (Bacitracin) (للعقديات بيتا-حالّة): حساسة = المجموعة A. مقاومة = المجموعة B.
- حساسية الأوبتوشين (Optochin) (للعقديات ألفا-حالّة): حساسة = S. pneumoniae. مقاومة = Viridans Streptococci.
📋 نصيحة عملية للطلاب
احفظ تحليل كتالاز وكواجولاز كأول اختبارين في خوارزميتك دائماً. الكتالاز يفصل بين العائلتين الكبريين، والكواجولاز يُحدّد هوية S. aureus مباشرة. هذان الاختباران وحدهما يكفيان للوصول إلى تشخيص مبدئي سليم في أكثر من 70% من الحالات.
📌 اقرأ أيضاً: لوي باستور: رائد علم الأحياء الدقيقة والمناعة
| الاختبار | الهدف التفريقي | نتيجة إيجابية | نتيجة سلبية | الوسط / الكاشف |
|---|---|---|---|---|
| الكتالاز (Catalase) | عنقوديات vs عقديات | Staphylococci | Streptococci / Enterococci | H₂O₂ (3%) |
| الكواجولاز (Coagulase) | S. aureus vs CoNS | S. aureus | S. epidermidis / S. saprophyticus | بلازما الأرنب |
| نوفوبيوسين (Novobiocin) | S. epidermidis vs S. saprophyticus | S. epidermidis (حساسة) | S. saprophyticus (مقاومة) | قرص Novobiocin |
| الباسيتراسين (Bacitracin) | المجموعة A vs المجموعة B | S. pyogenes (حساسة) | S. agalactiae (مقاومة) | قرص Bacitracin (A disk) |
| الأوبتوشين (Optochin) | S. pneumoniae vs Viridans | S. pneumoniae (حساسة) | Viridans Strep (مقاومة) | قرص Optochin (P disk) |
| الذوبان في الصفراء (Bile Solubility) | S. pneumoniae vs Viridans | S. pneumoniae (تذوب) | Viridans Strep (لا تذوب) | Sodium Deoxycholate (2%) |
| المصدر: American Society for Microbiology (ASM) – Manual of Clinical Microbiology | ||||
🔬 أداة التشخيص التفاعلية: حدد نوع المكورة إيجابية الغرام
كيف تخدع هذه البكتيريا جهاز المناعة وتقاوم المضادات الحيوية؟

الآليات المرضية (Pathogenesis) للمكورات إيجابية الغرام تتضمن أساليب متنوعة للتهرّب من جهاز المناعة. فالمحفظة عديدة السكاريد — كما في العقدية الرئوية — تمنع البلعمة. والبروتين A في المكورات العنقودية الذهبية يُعطّل الأجسام المضادة. والأغشية الحيوية (Biofilms) تحمي البكتيريا داخل حصون بيولوجية لا تصلها المضادات الحيوية بسهولة. ومنها أيضاً إنتاج إنزيم الستربتوكيناز (Streptokinase) الذي يُذيب الجلطات الدموية ليُتيح للبكتيريا الانتشار في الأنسجة.
لكن الفصل الأكثر إثارة للقلق في هذه القصة هو موضوع مقاومة المضادات الحيوية. إذاً كيف أصبحت مقاومة المكورات العنقودية للمضادات الحيوية كابوساً طبياً عالمياً؟
القصة بدأت مبكراً. فبعد سنوات قليلة من اكتشاف البنسلين في الأربعينيات، ظهرت سلالات من S. aureus تُنتج إنزيم البيتا لاكتاماز (β-lactamase) الذي يُكسّر حلقة البيتا لاكتام في البنسلين ويُبطل مفعوله. فطوّر العلماء الميثيسيلين (Methicillin) — وهو بنسلين مقاوم للبيتا لاكتاماز — لكن سرعان ما ظهرت في الستينيات سلالات مقاومة حتى لهذا المضاد الجديد. هذه السلالات هي المكورات العنقودية الذهبية المقاومة للميثيسيلين (MRSA).
آلية مقاومة MRSA ليست عبر إنزيم، بل عبر اكتساب جين mecA الذي يُشفّر بروتيناً بديلاً للربط بالبنسلين يُسمّى PBP2a (Penicillin-Binding Protein 2a). هذا البروتين البديل لا ترتبط به مضادات البيتا لاكتام، مما يجعل البكتيريا مقاومة لجميع أفراد هذه العائلة الواسعة.
وقد أثبتت دراسة منشورة في مجلة Clinical Microbiology Reviews عام 2018 أن معدلات MRSA في وحدات العناية المركزة في دول الخليج العربي تتراوح بين 12% و40% حسب المنطقة والمستشفى، مما يجعلها تحدياً إقليمياً يستوجب تضافر الجهود (Mediavilla, J. R., et al., 2012; بيانات محدّثة 2018-2023).
🚨 معلومة صادمة
ظهرت في السنوات الأخيرة سلالات من المكورات العنقودية الذهبية المقاومة للفانكومايسين (VRSA) — وهو المضاد الحيوي الذي كان يُعَدُّ “الملاذ الأخير” لعلاج MRSA. لحسن الحظ، لا تزال هذه السلالات نادرة جداً (أقل من 20 حالة مؤكدة عالمياً حتى 2024)، لكن مجرد وجودها يُنذر بمستقبل مقلق.
المصدر: CDC – Antibiotic Resistance Threats in the United States
📌 اقرأ أيضاً: ألكسندر فليمنج: مكتشف البنسلين
المكورات المعوية المقاومة للفانكومايسين (VRE): الكابوس الآخر

بينما تظل مقاومة المكورات العنقودية للفانكومايسين نادرة، فإن الوضع مختلف تماماً مع المكورات المعوية. فقد أصبحت المكورات المعوية المقاومة للفانكومايسين (Vancomycin-Resistant Enterococcus – VRE) مشكلة واسعة الانتشار في المستشفيات حول العالم. تكتسب هذه البكتيريا مقاومتها عبر جينات vanA أو vanB التي تُغيّر الهدف الجزيئي للفانكومايسين في جدار الخلية، فيفقد المضاد الحيوي قدرته على الارتباط.
الأخطر من ذلك أن هذه الجينات المقاومة تنتقل على عناصر وراثية متنقّلة (Transposons)، مما يعني إمكانية انتقالها أفقياً إلى أنواع بكتيرية أخرى — بما فيها المكورات العنقودية الذهبية. وهذا السيناريو هو بالضبط ما حدث في الحالات القليلة المُوثّقة لـ VRSA.
هل هناك أمل في مستقبل العلاج؟
من ناحية أخرى، لا يخلو المشهد من بوادر أمل. يعمل الباحثون حالياً على عدة بدائل واعدة تشمل: العلاج بالبكتيريوفاجات (Bacteriophage Therapy) وهي فيروسات تُهاجم البكتيريا بشكل نوعي دون أن تؤذي الخلايا البشرية. كذلك يُجرى بحث مكثف على الببتيدات المضادة للميكروبات (Antimicrobial Peptides – AMPs) المستوحاة من جزيئات المناعة الطبيعية. وهناك أيضاً مثبطات الضراوة (Anti-virulence agents) التي لا تقتل البكتيريا مباشرة بل تُجرّدها من أسلحتها، مما يُتيح لجهاز المناعة التعامل معها.
📌 اقرأ أيضاً: علم الأدوية (Pharmacology): دراسة تفاعل الأدوية مع الكائن الحي
| النمط المقاوم | البكتيريا | آلية المقاومة | الجين المسؤول | خيارات العلاج البديلة |
|---|---|---|---|---|
| MRSA | S. aureus | إنتاج PBP2a بديل لا يرتبط بالبيتا لاكتام | mecA | Vancomycin, Linezolid, Daptomycin |
| VRSA | S. aureus | تغيير الهدف الجزيئي D-Ala-D-Lac | vanA (مكتسب) | Linezolid, Daptomycin, Quinupristin-Dalfopristin |
| VRE | E. faecalis / E. faecium | تغيير الهدف الجزيئي للفانكومايسين | vanA أو vanB | Linezolid, Daptomycin, Tigecycline |
| PRSP | S. pneumoniae | طفرات في بروتينات الربط بالبنسلين (PBPs) | طفرات في pbp1a, pbp2b, pbp2x | Ceftriaxone, Vancomycin, Fluoroquinolones |
| المصادر: CDC – Antibiotic Resistance Threats Report | WHO – Bacterial Priority Pathogens List 2024 | ||||
كيف يمكن الوقاية من عدوى المكورات إيجابية الغرام في المستشفيات؟
مكافحة العدوى (Infection Control) في المستشفيات هي خطّ الدفاع الأول — وأحياناً الوحيد — ضد انتشار هذه البكتيريا العنيدة. لقد أثبتت التجربة السعودية أن تطبيق برامج مكافحة العدوى الصارمة يُحقّق نتائج ملحوظة. فمستشفيات وزارة الصحة والمستشفيات الجامعية في الرياض وجدة تطبّق بروتوكولات مبنية على إرشادات مراكز السيطرة على الأمراض والوقاية منها الأمريكية (CDC).
أبرز التدابير تشمل: نظافة اليدين المتكررة بالكحول أو الماء والصابون قبل وبعد كل تماس مع المريض — وهي الخطوة الأبسط والأكثر فاعلية. كذلك عزل المرضى المصابين بـ MRSA أو VRE في غرف فردية مع اتخاذ احتياطات التماس (Contact Precautions). ويُضاف إلى ذلك التعقيم الصارم للأسطح والأدوات الطبية، والاستخدام الرشيد للمضادات الحيوية (Antimicrobial Stewardship) لتقليل الضغط الانتقائي الذي يُشجّع ظهور المقاومة.
من المهم أيضاً إجراء المسح النشط (Active Surveillance) لحاملي MRSA بين المرضى الجدد في وحدات العناية المركزة، وتطبيق بروتوكول إزالة الاستعمار (Decolonization) باستخدام مرهم الموبيروسين (Mupirocin) للأنف وغسول الكلورهكسيدين (Chlorhexidine) للجلد.
💊 نصيحة عملية
إن كنت مريضاً أو مرافقاً في المستشفى، لا تتردد في تذكير الطاقم الطبي بتعقيم أيديهم قبل لمسك أو لمس مريضك. هذا ليس وقاحة — بل هو حقّك الصحي المشروع. الدراسات تُظهر أن نسبة التزام الكوادر الطبية بنظافة اليدين لا تتجاوز 40–60% في كثير من المستشفيات حول العالم إن لم تُوجد رقابة فعّالة.
المصدر: WHO – World Hand Hygiene Day / Clean Care is Safer Care
📌 اقرأ أيضاً: إدارة الأمراض المنقولة عن طريق الدم: الوقاية، العلاج، والتحديات
⚠️ حاسبة خطورة العدوى بالبكتيريا المقاومة (MRSA/VRE)
حدد عوامل الخطورة الموجودة لدى المريض:
⚠️ هذه الأداة تعليمية فقط ولا تُغني عن التقييم السريري | المصدر: CDC Antibiotic Resistance Report
سيناريو تطبيقي: كيف تتعامل مع عيّنة مخبرية خطوة بخطوة؟
دعني أنقلك إلى مختبر أحياء دقيقة في مستشفى تعليمي بالرياض. وصلتك عيّنة قيح (Pus) من خُرّاج جلدي لمريض يبلغ 35 عاماً.
أولاً: تُحضّر شريحة مجهرية وتُجري صبغة جرام. تحت المجهر، تظهر مكوّرات بنفسجية مرتّبة في عناقيد. إذاً أنت أمام مكورات إيجابية الغرام مرتّبة في عناقيد — مما يُشير مبدئياً إلى المكورات العنقودية.
ثانياً: تزرع العيّنة على آجار الدم. بعد 24 ساعة من الحضانة عند 37 درجة مئوية، تظهر مستعمرات صفراء ذهبية محاطة بمنطقة انحلال بيتا (شفافة). تزرع أيضاً على آجار المانيتول المالح (MSA)، فتلاحظ نمو مستعمرات صفراء — مما يعني أن البكتيريا تُخمّر المانيتول.
ثالثاً: تُجري اختبار الكتالاز. تضع قطرة H₂O₂ على المستعمرة — تظهر فقاعات فوراً. النتيجة: إيجابية الكتالاز. هذا يؤكد أنها عنقودية.
رابعاً: تُجري اختبار الكواجولاز. تخلط المستعمرة مع بلازما أرنب في أنبوب. بعد 4 ساعات، تلاحظ تخثّر البلازما. النتيجة: إيجابية الكواجولاز. التشخيص النهائي: Staphylococcus aureus.
خامساً: تُجري اختبار الحساسية للمضادات الحيوية (Antibiotic Susceptibility Testing). تلاحظ مقاومة للأوكساسيلين (Oxacillin) — وهو الاختبار البديل للميثيسيلين. النتيجة: MRSA. يُبلَّغ الطبيب فوراً لتعديل الخطة العلاجية واستخدام الفانكومايسين أو اللينزوليد (Linezolid).
هذا السيناريو يُلخّص بالضبط ما يحدث يومياً في مختبرات الأحياء الدقيقة حول العالم. وهو يُوضّح كيف أن الخطوات المنهجية البسيطة — صبغة جرام، كتالاز، كواجولاز — تقود إلى تشخيص دقيق يُنقذ حياة المريض.
📌 اقرأ أيضاً: الإحصاءات الحيوية (Vital Statistics): المفهوم، الأهمية، والتطبيقات
🧪 اختبر معلوماتك!
ما هو الاختبار المخبري الأول الذي يفصل بين المكورات العنقودية والمكورات العقدية؟
❓ الأسئلة الشائعة حول المكورات إيجابية الغرام
هل المكورات إيجابية الغرام معدية؟ +
نعم، معظمها معدٍ وينتقل عبر التماس المباشر مع المصاب أو الأسطح الملوثة أو الرذاذ التنفسي. S. aureus تنتقل باللمس، بينما S. pneumoniae تنتقل عبر السعال والعطس. نظافة اليدين أهم وسيلة وقائية.
ما الفرق بين البكتيريا إيجابية الغرام وسلبية الغرام في العلاج؟ +
إيجابية الغرام تستجيب عادةً للبنسلين والفانكومايسين، بينما سلبية الغرام تحتاج مضادات مختلفة كالسيفالوسبورينات والأمينوجليكوزيدات. الغشاء الخارجي في سلبية الغرام يمنع دخول كثير من المضادات.
هل يمكن علاج MRSA بالمضادات الحيوية العادية؟ +
لا، MRSA مقاومة لجميع مضادات البيتا لاكتام (البنسلين والسيفالوسبورينات). تحتاج مضادات خاصة مثل الفانكومايسين أو اللينزوليد أو الدابتومايسين تحت إشراف طبي متخصص.
كم تستغرق نتيجة زراعة المكورات إيجابية الغرام؟ +
عادةً 24-48 ساعة للنمو الأولي على آجار الدم. اختبار الحساسية للمضادات الحيوية يحتاج 24 ساعة إضافية. النتيجة النهائية الكاملة تصل خلال 48-72 ساعة من استلام العينة.
هل المكورات العنقودية الذهبية موجودة طبيعياً في الجسم؟ +
نعم، حوالي 30% من البشر يحملون S. aureus في أنوفهم دون أعراض. تصبح مُمرضة فقط حين تدخل الجروح أو مجرى الدم أو عند ضعف المناعة.
ما أعراض عدوى المكورات إيجابية الغرام الجلدية؟ +
احمرار وتورم وألم موضعي وسخونة في المنطقة المصابة. قد يتكون خراج مملوء بالقيح. في الحالات الشديدة تظهر حمى وقشعريرة تدل على انتشار العدوى.
هل لقاح المكورات الرئوية ضروري للبالغين؟ +
ضروري لمن تجاوز 65 عاماً ولأصحاب الأمراض المزمنة (السكري، أمراض القلب والرئة، ضعف المناعة). يوصي CDC بلقاح PCV20 أو PCV15 متبوعاً بـ PPSV23.
ما الفرق بين التهاب الحلق الفيروسي والبكتيري (العقدي)؟ +
البكتيري (العقدي) يتميز بألم شديد مفاجئ وحمى عالية وبقع بيضاء على اللوزتين وتضخم الغدد اللمفاوية دون سعال أو رشح. يحتاج مسحة حلق للتأكيد ومضاداً حيوياً للعلاج.
هل العسل فعال ضد المكورات إيجابية الغرام؟ +
أظهرت دراسات مخبرية أن عسل مانوكا يمتلك نشاطاً مضاداً لـ S. aureus وMRSA موضعياً. لكنه علاج مساعد فقط ولا يُغني عن المضادات الحيوية في العدوى الجهازية.
متى يجب عزل مريض MRSA في المستشفى؟ +
فور تأكيد الإصابة أو حتى الاشتباه القوي. يُوضع في غرفة فردية مع تطبيق احتياطات التماس: قفازات وعباءة عند الدخول، وتعقيم الأسطح والأدوات الخاصة به.
خلاصة: لماذا يجب أن تفهم هذه البكتيريا جيداً؟
لقد استعرضنا في هذا المقال عالم المكورات إيجابية الغرام من جوانبه كافة: من البنية التشريحية لجدارها الخلوي السميك الذي يُعطيها لونها البنفسجي المميز، إلى تصنيفها العلمي القائم على اختبارات بسيطة كالكتالاز والكواجولاز. تعرّفنا على المكورات العنقودية بأنواعها وعوامل ضراوتها المتعددة، وعلى المكورات العقدية بمجموعاتها المختلفة وأمراضها التي تمتد من التهاب الحلق البسيط إلى التهاب اللفافة الناخر. وكذلك ناقشنا المكورات المعوية التي تحوّلت من بكتيريا نافعة إلى عدوّ مقاوم في المستشفيات.
إن فهم هذه المجموعة البكتيرية ليس ترفاً أكاديمياً. فكل يوم في مستشفيات المملكة العربية السعودية والعالم العربي، يُتّخذ قرار علاجي بناءً على نتيجة صبغة جرام ونتيجة اختبار الكتالاز. كل يوم يُنقذ تشخيص مخبري سليم حياة مريض بالتفريق بين بكتيريا تستجيب للبنسلين وأخرى تحتاج الفانكومايسين. فهل يمكنك الآن التمييز بين المكورات العنقودية والعقدية تحت المجهر؟
إن كنت تريد استكمال الصورة، فإن الخطوة التالية هي فهم الجانب الآخر: البكتيريا سلبية الغرام وبنية غشائها الخارجي المختلف تماماً — وكيف يؤثر ذلك على اختيار المضادات الحيوية.
إن وجدت هذا المقال مفيداً لدراستك أو عملك المخبري، فشاركه مع زملائك في كلية الطب أو المختبر. وإن كان لديك سؤال عن حالة سريرية أو اختبار مخبري محدّد، فاتركه في التعليقات وسنُجيب عنه بأسرع وقت. المعرفة الطبية الدقيقة يجب ألا تبقى حكراً على الكتب المرجعية الثقيلة — بل يجب أن تصل إلى كل من يحتاجها.
قاموس المصطلحات العلمية الواردة في المقال
البنية الخلوية والجدار البكتيري
1. الببتيدوجليكان (Peptidoglycan)
التعريف: بوليمر سكري-ببتيدي يُشكّل الهيكل الأساسي لجدار الخلية البكتيرية، ويمنحها الصلابة والحماية الميكانيكية ضد الانفجار الأسموزي.
تبسيط: تخيّله كشبكة أسلاك حديدية تُحيط بالخلية وتحميها من الانهيار، كلما زاد عدد الطبقات زادت المتانة.
2. أحماض التيكويك (Teichoic Acids)
التعريف: بوليمرات فوسفاتية موجودة حصرياً في جدار البكتيريا إيجابية الغرام، تُساهم في الالتصاق بالأنسجة وتنظيم مرور الأيونات وإثارة الاستجابة المناعية.
3. أحماض ليبوتيكويك (Lipoteichoic Acids)
التعريف: نوع من أحماض التيكويك مُثبَّت في الغشاء الخلوي ويمتد عبر طبقة الببتيدوجليكان نحو السطح الخارجي للخلية.
4. جدار الخلية البكتيرية (Bacterial Cell Wall)
التعريف: غلاف صلب يُحيط بالغشاء البلازمي للبكتيريا، يحدد شكل الخلية ويحميها، ويختلف تركيبه بين البكتيريا إيجابية وسلبية الغرام.
5. غشاء البلازما (Plasma Membrane)
التعريف: غشاء دهني مزدوج الطبقة يُحيط بالسيتوبلازم ويتحكّم في دخول وخروج المواد من الخلية وإليها.
6. الأغشية الحيوية (Biofilms)
التعريف: مجتمعات بكتيرية مُنظَّمة تلتصق بالأسطح وتُحيط نفسها بمصفوفة لزجة من عديدات السكاريد، مما يجعلها شديدة المقاومة للمضادات الحيوية وجهاز المناعة.
تبسيط: تخيّلها كقلعة محصّنة بنتها البكتيريا حول نفسها على سطح قسطرة أو مفصل صناعي.
التقنيات التشخيصية والصبغات
7. صبغة جرام (Gram Stain)
التعريف: تقنية تلوين تفريقية اخترعها هانس كريستيان غرام عام 1884، تُقسّم البكتيريا إلى مجموعتين بناءً على بنية جدارها الخلوي: إيجابية الغرام (بنفسجية) وسلبية الغرام (وردية/حمراء).
8. البنفسج البلوري (Crystal Violet)
التعريف: الصبغة الأولية المُستخدمة في صبغة جرام، تلوّن جميع البكتيريا باللون البنفسجي في البداية قبل مرحلة إزالة اللون بالكحول.
9. السافرانين (Safranin)
التعريف: الصبغة المقابلة (Counter Stain) في صبغة جرام، تُعطي اللون الأحمر/الوردي للبكتيريا سلبية الغرام التي فقدت البنفسج البلوري.
10. اختبار الكتالاز (Catalase Test)
التعريف: اختبار بيوكيميائي يكشف عن وجود إنزيم الكتالاز الذي يُحلّل بيروكسيد الهيدروجين إلى ماء وأكسجين. يُفرّق بين العنقوديات (إيجابية) والعقديات (سلبية).
11. اختبار الكواجولاز (Coagulase Test)
التعريف: اختبار يكشف قدرة البكتيريا على تحويل الفيبرينوجين إلى فيبرين (تخثّر البلازما). يُميّز S. aureus (إيجابية) عن بقية العنقوديات (سلبية).
12. آجار الدم (Blood Agar)
التعريف: وسط زراعة بكتيرية غني يحتوي على 5% دم غنم، يُستخدم لملاحظة أنماط انحلال الدم (ألفا، بيتا، جاما) حول المستعمرات البكتيرية.
13. آجار المانيتول المالح (Mannitol Salt Agar – MSA)
التعريف: وسط زراعة انتقائي وتفريقي يحتوي على تركيز عالٍ من الملح (7.5% NaCl) يسمح بنمو المكورات العنقودية فقط، ويكشف قدرتها على تخمير المانيتول.
التصنيف البكتيري والمجموعات
14. تصنيف لانسفيلد (Lancefield Grouping)
التعريف: نظام تصنيف للمكورات العقدية ابتكرته ريبيكا لانسفيلد، يعتمد على نوع الكربوهيدرات السطحية (المستضد C) ويُقسّمها إلى مجموعات (A, B, C… إلخ).
15. انحلال الدم (Hemolysis)
التعريف: قدرة البكتيريا على تحلّل كريات الدم الحمراء في وسط آجار الدم. تنقسم إلى: بيتا (تحلّل كامل)، ألفا (تحلّل جزئي)، وجاما (لا تحلّل).
16. المستضد الفائق (Superantigen)
التعريف: بروتين بكتيري يُنشّط نسبة هائلة من الخلايا التائية (تصل إلى 20%) دفعة واحدة دون الحاجة للمعالجة المستضدية التقليدية، مما يُسبّب عاصفة سيتوكينية قد تكون مميتة.
تبسيط: بدلاً من تنشيط جندي واحد، ينشّط جيشاً كاملاً دفعة واحدة فيحدث فوضى عارمة في الجسم.
عوامل الضراوة والإمراض
17. إنزيم الكواجولاز (Coagulase Enzyme)
التعريف: إنزيم تُنتجه S. aureus يُحوّل الفيبرينوجين إلى فيبرين، فيُشكّل درعاً من الجلطات الدقيقة حول البكتيريا يحميها من البلعمة المناعية.
18. البروتين A (Protein A)
التعريف: بروتين سطحي في S. aureus يرتبط بالجزء Fc من الأجسام المضادة IgG بشكل معكوس، فيُعطّل وظيفتها في تنشيط البلعمة (Opsonization).
19. السموم المعوية (Enterotoxins)
التعريف: ذيفانات بكتيرية مقاومة للحرارة تُنتجها S. aureus وتُسبّب تسمماً غذائياً سريعاً (1–6 ساعات) عبر تحفيز مركز القيء في الدماغ.
20. المحفظة عديدة السكاريد (Polysaccharide Capsule)
التعريف: غلاف هلامي خارجي يُحيط ببعض البكتيريا (مثل S. pneumoniae)، يمنع البلعمة ويُحدّد النمط المصلي للبكتيريا.
21. الستربتوكيناز (Streptokinase)
التعريف: إنزيم تُنتجه بعض العقديات يُحوّل البلازمينوجين إلى بلازمين، فيُذيب الجلطات الدموية ويُسهّل انتشار البكتيريا في الأنسجة.
المقاومة للمضادات الحيوية
22. MRSA (Methicillin-Resistant Staphylococcus aureus)
التعريف: سلالات من المكورات العنقودية الذهبية اكتسبت جين mecA الذي يُشفّر بروتين PBP2a البديل، مما يجعلها مقاومة لجميع مضادات البيتا لاكتام.
23. PBP2a (Penicillin-Binding Protein 2a)
التعريف: بروتين بديل للربط بالبنسلين تُنتجه سلالات MRSA، لا ترتبط به مضادات البيتا لاكتام فتفقد قدرتها على تعطيل بناء الجدار الخلوي.
تبسيط: كأن البكتيريا غيّرت القفل على بابها، فلم يعد المفتاح القديم (البنسلين) يعمل.
24. VRE (Vancomycin-Resistant Enterococcus)
التعريف: مكورات معوية اكتسبت جينات vanA أو vanB التي تُغيّر الهدف الجزيئي للفانكومايسين في الجدار الخلوي.
25. البيتا لاكتاماز (β-lactamase)
التعريف: إنزيم تُنتجه بعض البكتيريا يُكسّر حلقة البيتا لاكتام في البنسلين والمضادات الحيوية المشابهة، مما يُبطل مفعولها.
الأمراض والمتلازمات
26. التهاب اللفافة الناخر (Necrotizing Fasciitis)
التعريف: عدوى بكتيرية خطيرة تُدمّر الأنسجة الرخوة العميقة (اللفافة) بسرعة كبيرة، تُعرف إعلامياً بـ”البكتيريا آكلة اللحم”، وتحمل نسبة وفيات مرتفعة (20–40%).
27. الحمى الروماتيزمية (Rheumatic Fever)
التعريف: مضاعفة مناعية تالية لعدوى العقدية المقيّحة غير المُعالجة، تُهاجم فيها الأجسام المضادة أنسجة القلب والمفاصل بالخطأ (التفاعل المتصالب).
28. متلازمة الصدمة السمّية (Toxic Shock Syndrome – TSS)
التعريف: حالة طبية حادة ومهددة للحياة تنتج عن ذيفان TSST-1 الذي تُنتجه S. aureus، يعمل كمستضد فائق ويُسبّب هبوطاً حاداً في ضغط الدم وفشلاً متعدد الأعضاء.
مكافحة العدوى والعلاج
29. البكتيريوفاجات (Bacteriophages)
التعريف: فيروسات تُهاجم البكتيريا بشكل نوعي دون أن تؤذي الخلايا البشرية، يُدرس استخدامها كبديل واعد للمضادات الحيوية خاصة ضد البكتيريا المقاومة.
30. إزالة الاستعمار (Decolonization)
التعريف: بروتوكول وقائي يهدف إلى القضاء على البكتيريا المُستوطنة (مثل MRSA) من جسم المريض الحامل لها دون أعراض، باستخدام مرهم الموبيروسين للأنف وغسول الكلورهكسيدين للجلد.
المصادر والمراجع
الدراسات والأوراق البحثية
- Brown, S., Santa Maria, J. P., & Walker, S. (2013). Wall teichoic acids of gram-positive bacteria. Annual Review of Microbiology, 67, 313–336.
https://doi.org/10.1146/annurev-micro-092412-155620
مراجعة شاملة لدور أحماض التيكويك في بنية الجدار الخلوي والمقاومة للمضادات الحيوية. - Lynskey, S. J., Lawrenson, R. A., Sherr, M. A., Sherr, A. L., & Sriskandan, S. (2019). New understandings in Streptococcus pyogenes. Current Opinion in Infectious Diseases, 32(3), 185–192.
https://doi.org/10.1097/QCO.0000000000000541
تستعرض الآليات الجديدة لضراوة العقدية المقيّحة وسلالاتها الغازية. - Turner, N. A., Sharma-Kuinkel, B. K., Maskarinec, S. A., Eichenberger, E. M., Shah, P. P., Carugati, M., … & Fowler, V. G. (2019). Methicillin-resistant Staphylococcus aureus: an overview of basic and clinical research. Nature Reviews Microbiology, 17(4), 203–218.
https://doi.org/10.1038/s41579-018-0147-4
مرجع أساسي حول MRSA من الأساس الجزيئي إلى التحديات السريرية. - Weiner-Lastinger, L. M., Abner, S., Edwards, J. R., Kallen, A. J., Karlsson, M., Magill, S. S., … & Dudeck, M. A. (2020). Antimicrobial-resistant pathogens associated with adult healthcare-associated infections: Summary of data reported to the National Healthcare Safety Network, 2015–2017. Infection Control & Hospital Epidemiology, 41(1), 1–18.
https://doi.org/10.1017/ice.2019.296
بيانات وبائية حديثة عن معدلات مقاومة المضادات الحيوية في المستشفيات الأمريكية. - Bolukaoto, J. Y., Monyama, C. M., Chukwu, M. O., Lekala, S. M., Nchabeleng, M., Maloba, M. R. B., … & Chaimane, A. (2021). Antibiotic resistance of Streptococcus agalactiae isolated from pregnant women in Garankuwa, South Africa. BMC Research Notes, 14, 85.
https://doi.org/10.1186/s13104-021-05496-0
دراسة عن مقاومة العقدية القاطعة للدر للمضادات الحيوية لدى الحوامل. - Cattoir, V., & Leclercq, R. (2013). Twenty-five years of shared life with vancomycin-resistant enterococci. Journal of Antimicrobial Chemotherapy, 68(4), 731–742.
https://doi.org/10.1093/jac/dks468
مراجعة تاريخية وعلمية لمقاومة المكورات المعوية للفانكومايسين.
الجهات الرسمية والمنظمات
- World Health Organization (WHO). (2024). Bacterial Priority Pathogens List, 2024.
https://www.who.int/publications/i/item/9789240093461
قائمة الممرضات البكتيرية ذات الأولوية عالمياً حسب خطورة المقاومة. - Centers for Disease Control and Prevention (CDC). (2024). Antibiotic Resistance Threats in the United States.
https://www.cdc.gov/antimicrobial-resistance/data-research/threats/index.html
تقرير شامل عن التهديدات الناجمة عن المقاومة البكتيرية في الولايات المتحدة. - National Institutes of Health (NIH). (2023). NIAID’s role in research on antimicrobial resistance.
https://www.niaid.nih.gov/research/antimicrobial-resistance
ملخّص جهود المعاهد الوطنية الأمريكية في مكافحة المقاومة البكتيرية. - Saudi CDC (Weqaya). (2023). National Infection Prevention and Control Guidelines.
https://covid19.cdc.gov.sa/
الإرشادات الوطنية السعودية لمكافحة العدوى في المنشآت الصحية. - European Centre for Disease Prevention and Control (ECDC). (2023). Antimicrobial resistance surveillance in Europe.
https://www.ecdc.europa.eu/en/antimicrobial-resistance
بيانات المراقبة الأوروبية لمقاومة المضادات الحيوية.
الكتب والموسوعات العلمية
- Murray, P. R., Rosenthal, K. S., & Pfaller, M. A. (2021). Medical Microbiology (9th ed.). Elsevier.
من أشهر الكتب المرجعية في علم الأحياء الدقيقة الطبية لطلاب الطب. - Carroll, K. C., Butel, J. S., & Morse, S. A. (2019). Jawetz, Melnick, & Adelberg’s Medical Microbiology (28th ed.). McGraw-Hill Education.
كتاب كلاسيكي يُغطي الأحياء الدقيقة الأساسية والسريرية. - Mandell, G. L., Bennett, J. E., & Dolin, R. (2020). Mandell, Douglas, and Bennett’s Principles and Practice of Infectious Diseases (9th ed.). Elsevier.
الموسوعة الأضخم في الأمراض المعدية، ويُعَدُّ مرجعاً نهائياً للممارسين.
مقالات علمية مبسطة
- Lowy, F. D. (2003). Antimicrobial resistance: the example of Staphylococcus aureus. Scientific American, 288(4), 46–53.
مقالة مبسّطة تشرح قصة مقاومة المكورات العنقودية الذهبية بأسلوب علمي سهل.
قراءات إضافية ومصادر للتوسّع
- Crossley, K. B., Jefferson, K. K., Archer, G. L., & Fowler, V. G. (Eds.). (2009). Staphylococci in Human Disease (2nd ed.). Wiley-Blackwell.
لماذا نقترح عليك قراءته؟ هذا الكتاب يُعَدُّ المرجع الأشمل المخصّص حصرياً للمكورات العنقودية بأنواعها كافة، ويُغطي كل شيء من البيولوجيا الجزيئية إلى الأوبئة والعلاج. مثالي لمن يُريد التعمّق بعد قراءة مقالنا. - Ferretti, J. J., Stevens, D. L., & Fischetti, V. A. (Eds.). (2016). Streptococcus pyogenes: Basic Biology to Clinical Manifestations. University of Oklahoma Health Sciences Center.
https://www.ncbi.nlm.nih.gov/books/NBK333424/
لماذا نقترح عليك قراءته؟ كتاب إلكتروني مجاني متاح على PubMed Bookshelf، يُغطي العقدية المقيّحة من الجينوم إلى السرير بتفصيل أكاديمي استثنائي. لا غنى عنه لطلاب الدراسات العليا. - Arias, C. A., & Murray, B. E. (2012). The rise of the Enterococcus: beyond vancomycin resistance. Nature Reviews Microbiology, 10(4), 266–278.
https://doi.org/10.1038/nrmicro2761
لماذا نقترح عليك قراءته؟ ورقة مراجعة بارزة تُفسّر كيف تحوّلت المكورات المعوية من بكتيريا مُهملة إلى تهديد مستشفوي عالمي. تعطي منظوراً تاريخياً وبيولوجياً عميقاً يُكمل ما ناقشناه.
هل أنت مستعد الآن لفهم الجانب الآخر من عالم البكتيريا — البكتيريا سلبية الغرام وجدارها ذي الغشاء الخارجي المزدوج؟
📄 بروتوكولات ودلائل إرشادية رسمية ذات صلة
- منظمة الصحة العالمية (WHO) — قائمة الممرضات البكتيرية ذات الأولوية 2024: تُصنّف MRSA و VRE ضمن الممرضات عالية الأولوية التي تستلزم تطوير مضادات حيوية جديدة.
- مراكز السيطرة على الأمراض والوقاية منها (CDC) — إرشادات نظافة اليدين في المنشآت الصحية 2024: تُحدّد المعايير الذهبية لنظافة اليدين كأهم إجراء لمكافحة انتقال MRSA و VRE بين المرضى.
- وزارة الصحة السعودية — الدليل الوطني لمكافحة العدوى 2023: يتضمن بروتوكولات عزل المرضى المصابين بالبكتيريا المقاومة وإجراءات التعقيم في وحدات العناية المركزة.
- وزارة الصحة ووقاية المجتمع الإماراتية — برنامج الترصد الوبائي للمقاومة البكتيرية: يُراقب معدلات MRSA و VRE في المنشآت الصحية الإماراتية ويُصدر تقارير دورية.
🛡️ بيان المصداقية
يلتزم فريق موسوعة خلية العلمية بأعلى معايير الدقة والموثوقية في المحتوى العلمي المنشور. تستند جميع المعلومات الواردة في هذا المقال إلى:
- دراسات وأوراق بحثية محكَّمة منشورة في مجلات علمية مرموقة.
- تقارير وإرشادات صادرة عن جهات رسمية مثل منظمة الصحة العالمية (WHO) ومراكز السيطرة على الأمراض (CDC).
- كتب مرجعية أكاديمية معتمدة في علم الأحياء الدقيقة الطبية.
تخضع مقالاتنا لعملية مراجعة علمية متعددة المراحل لضمان جودة المعلومات وحداثتها ومطابقتها للمعايير العلمية العالمية.
⚠️ تحذير وإخلاء مسؤولية
المعلومات الواردة في هذا المقال مُقدَّمة لأغراض تعليمية وتثقيفية بحتة من قِبَل موسوعة خلية العلمية، ولا تُشكّل بأي حال من الأحوال بديلاً عن الاستشارة الطبية المتخصصة أو التشخيص أو العلاج من قِبَل طبيب أو أخصائي أحياء دقيقة مؤهَّل.
لا ينبغي الاعتماد على محتوى هذا المقال لاتخاذ قرارات تشخيصية أو علاجية دون الرجوع إلى مقدّم الرعاية الصحية المختص. كل حالة طبية فريدة وتتطلب تقييماً سريرياً فردياً.
موسوعة خلية العلمية لا تتحمّل أي مسؤولية عن أي ضرر مباشر أو غير مباشر ينتج عن استخدام أو سوء استخدام المعلومات المنشورة في هذا المقال.
✅ مقالة مُراجَعة علمياً
جرت مراجعة هذا المقال من قِبَل هيئة التحرير العلمية في موسوعة خلية العلمية لضمان الدقة والمعلومة الصحيحة.
آخر تحديث: يناير 2026
هل لديك ملاحظة أو تصحيح علمي؟ تواصل معنا
✅ مقال مُراجَع ومُدقَّق علمياً
تمت مراجعة هذا المقال وتدقيقه من قبل هيئة التحرير العلمية في موسوعة خلية وفقاً لسياسة التحقق والمراجعة العلمية المعتمدة.
آخر تحديث: يناير 2026 | khalieah.com




